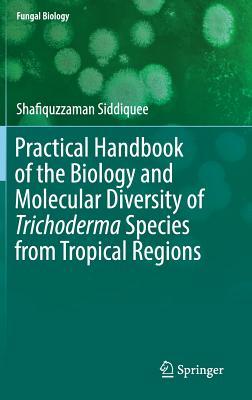
Download Practical Handbook of the Biology and Molecular Diversity of Trichoderma Species from Tropical Regions - Shafiquzzaman Siddiquee | PDF

Full Download Practical Handbook of the Biology and Molecular Diversity of Trichoderma Species from Tropical Regions - Shafiquzzaman Siddiquee file in ePub
Related searches:
Practical Handbook of the Biology and Molecular - Springer
Practical Handbook of the Biology and Molecular Diversity of Trichoderma Species from Tropical Regions
Practical Handbook of the Biology and Molecular - Amazon.com
AS and A-level Biology Practicals handbook - Mark Scheme - AQA
CRC Practical Handbook of Biochemistry and Molecular Biology
Practical handbook of biochemistry and molecular biology; Edited by
Practical Handbook of Soybean Processing and Utilization - 1st
E-book PDF The Biology of Ageing: A Practical Handbook: a
AQA A Level Biology Practical Handbook - The Polesworth School
Handbook practical logic and automated reasoning Programming
A Handbook of Tropical Soil Biology: Sampling and Characterization
Practical Manual on Plant Molecular Biology and Analytical
Making And Using Antibodies A Practical Handbook - Worth Avenue
The book is divided broadly into five sections: an introduction; two sections on the culture and characterisation of human pluripotent stem cells; and two sections.
Com ✓ free shipping on discover delightful children's books with amazon book box, a subscription that.
Start reading practical handbook of microbiology for free online and get access to an unlimited library of academic and non-fiction books on perlego.
Trophic dynamics, system productivity, physical-chemical-biological alteration, and coastal resource management.
The practical handbook of microbiology presents basic knowledge about working with microorganisms in a clear and concise form.
Bestseller books� tag: uttam publication psychology – important question bank for maharashtra hsc board exam 2017.
Practical handbook of the biology and molecular diversity of trichoderma species from tropical regions (fungal biology) - kindle edition by siddiquee,.
The book: addresses the new format of kcse biology practical paper which lays emphasis on photographs based questions.
Practical manual on plant molecular biology and analytical techniques.
Practical physicsmodern statistics for modern biologythe college handbook1000 solved.
This practical handbook describes sampling and laboratory assessment methods for the biodiversity of a number of key functional groups of soil organisms,.
This handbook offers guidance for teachers on the central issues of the prescribed practical activities in the leaving certificate biology syllabus.
Practical handbook of microbiology, 4th edition provides basic, clear and concise knowledge and practical information about working with microorganisms.
Long-term storage of cryopreserved hematopoietic cells and their recovery after thawing are of critical importance in both traditional and novel cellular therapies.
Yeah, reviewing a ebook making and using antibodies a practical handbook second edition could go to your near friends listings.
After two decades of teaching the two-semester sequence of general biology courses, requiring students to purchase a hefty textbook at a high cost that.
Practical handbook of biochemistry and molecular biology; edited by g d fasman.
This book analyzes the right pathway to solve the controversial identifications of some trichoderma species on the basis of sampling procedures, slide.
Crc practical handbook of biochemistry and molecular biology; find sigma- aldrich-c3671 msds, related peer-reviewed papers, technical documents, similar.
This practical handbook is an attempt to harmonise the rules and guidance for biology, chemistry and physics.
Post Your Comments: